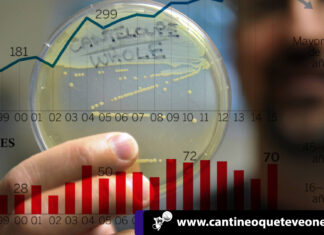
España es el tercer país de la UE con más casos de Listeria listeria-españa-enfermedad-peligrosa

El Papa muestra su apoyo para que Macedonia del Norte entre a la UE
El Papa ha demostrado su apoyo al país Macedonia del Norte, que lleva casi quince años en negociaciones con Bruselas; el país ha llegado incluso a cambiar su nombre en 2018 para así poner...
Cineasta francés adapta al cine exitosa novela de David Foenkinos
El cineasta Francés Rémi Bezançon adapta en el cine la novela del exitoso David Foenkinos; sus libros han sido adaptados al cine en varias ocasiones.
Esto cautivo al cineasta francés, porque le recordó de alguna...
¡Bienvenido! Real Madrid ya tiene a Eden Hazard en sus filas
Todo indica que en las próximas horas Eden Hazard esté en el Santiago Bernabéu para su presentación con el Real Madrid. Ya el equipo blanco tiene a un delantero más que le dará fuerzas...
Trata sexual de venezolanas en España aumenta sus cifras
Según el Ministerio del Interior de España, Venezuela se posiciona como tercer país, tras Colombia y Nigeria; del cual son oriundas de las víctimas de trata sexual en España. Esta es la primera vez que...
Corrupción en España resta 60.000 millones en ingresos anuales
Anualmente, la corrupción en España, engulle unos 1,2 billones de euros; cifra que representa un 1,25% de la riqueza mundial; ademas del equivalente del PIB del país. Estos datos revelados en un estudio del FMI,...
España es el tercer país de la UE con más casos de Listeria
En España es el tercer país con más casos de la enfermedad listeria, ya han ingresado pacientes en hospitales de Liverpool y Manchester; y han muerto luego de consumir bocadillos de pollo contaminados. España en...
«O Son Do Camiño» y su apuesta gallega, Marem Ladson
Ivan Méndez; director de O Son Do Camiño apuesta fuertemente a su escena gallega, para la segunda edición de su festival.
Indica que el porcentaje de las bandas regionales que participan en este festival ronda...
BCV anunció incorporación de tres nuevos billetes
El Banco Central de Venezuela dio el anuncio de tres nuevos billetes para el cono monetario. Los tres nuevos billetes entrarán en circulación desde el 13 de junio y serán los primeros de mayor...
Elecciones en España: ¿Quién ganó? ¿Qué se espera que suceda ahora?
Según los resultados de las elecciones en España, se dio a conocer la gran participación popular para la eventualidad democrática; la cual demostró, de modo definitivo, la tendencia y responsabilidad participativa de los españoles. Con...
Rodrigo Blanco Calderón galardonado en el Bienal de Novela Vargas Llosa
El literato Rodrigo Blanco Calderón, durante la clausura, en el Conjunto Santander de las Artes de Guadalajara; consiguió los 109.000 dólares del premio y una estatuilla en el Bienal de Novela Vargas Llosa, Rodrigo Blanco Calderón,...